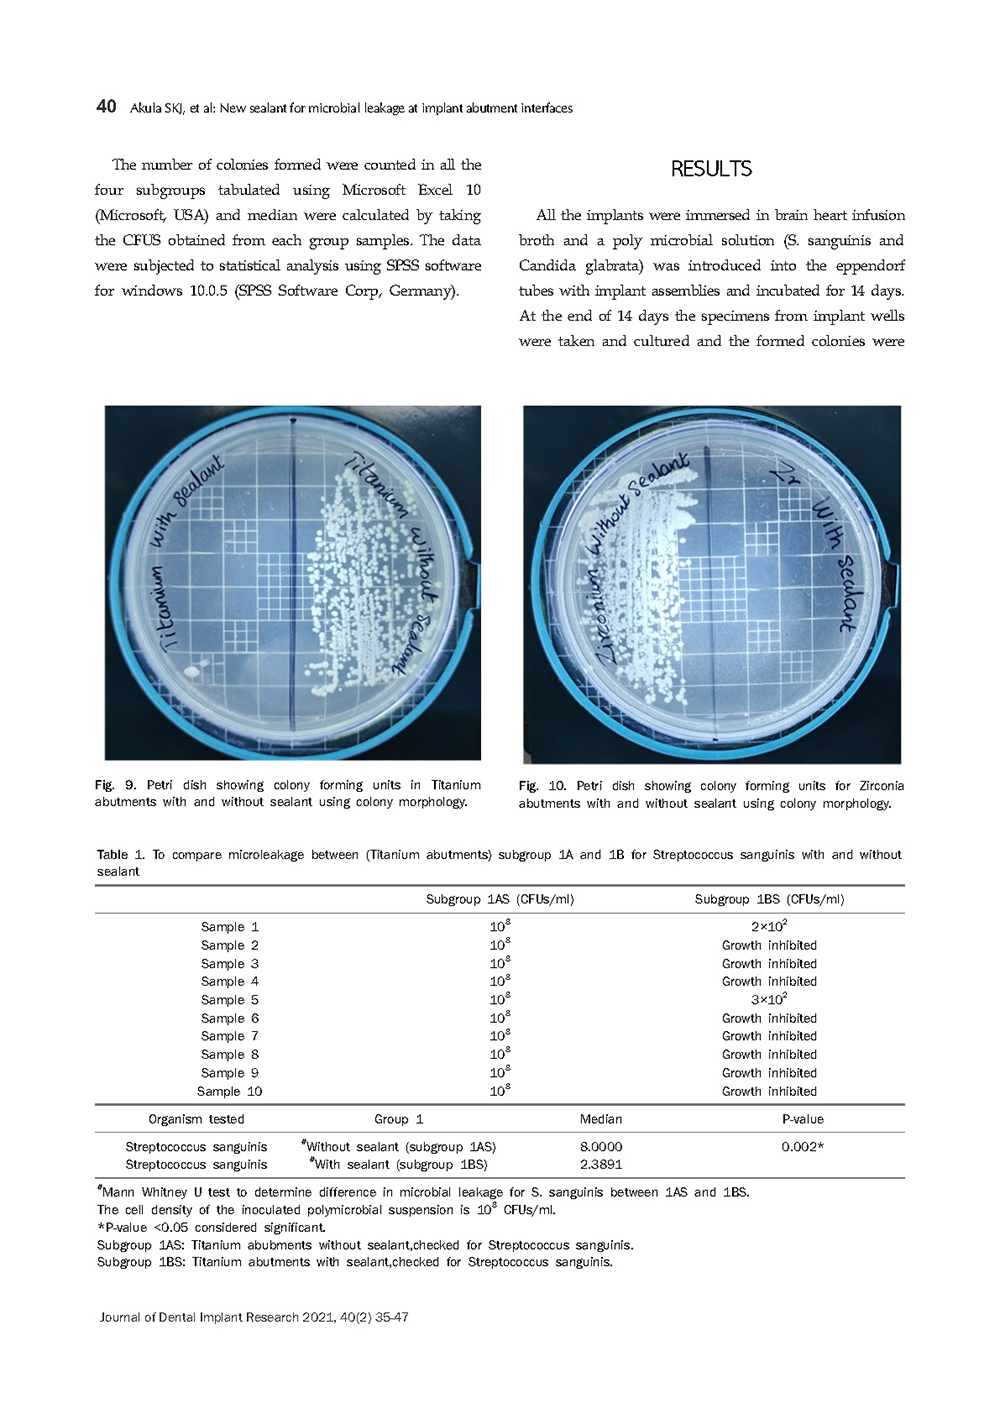

DSI Viruseal

DSI ViruSeal הוא ג'ל חדש וייחודי לחלוטין המשמש לאיטום שתלים. אין בשוק אנלוגים או מוצרים שדומים לג'ל זה אפילו במקצת! זהו מוצר מהפכני שהתפתח ברפואת השיניים המודרנית של ימינו.
כל כירורג דנטלי העוסק בהשתלות נתקל במוקדם או במאוחר בזיהומים באזור של השתל. מצבים פתלוגיים אלו של דלקת ברקמות הרכות סביב השתל הופכים לבעיה אמיתית. בדומה למבנה של השן הטבעית, החיידקים מתרבים במהירות, וללא שליטה, על בסיס השתל ומתחת לקו החניכיים. דבר זה מגרה באופן קבוע את רקמת החניכיים, ועם הזמן הופך לדלקת ומתחיל לפגוע ברקמות הבריאות. בשלבים המאוחרים זה יכול לגרום למבנה העצם להתדרדר מתחת לשתל.
שלבי הדלקת:
1. התרבות חיידקים וגירוי רקמות.
2. תגובת הגוף של המטופל למחלת חניכיים.
3. תהליך דלקת הרסני, הפוגע ברקמות הרכות והקשות סביב השתל הדנטלי.
DSI ViruSeal הוא חומר אנטי-בקטריאלי יעיל ביותר המבוסס על מטריצת סיליקון צמיגה. החומר סוגר מיקרו-פערים במערכות השתלים הדו-רכיביים וגורם להפסקת מיקרו-תזוזות, מה שהופך את האזור לבלתי-חדיר עבור חיידקים ומונע זיהום.
זה למה DSI ViruSeal הוא פריט חובה! הפרקטיקה הרפואית שלך והמטופלים שלך הם הנכסים החשובים ביותר בקריירה – אל תזלזל בהם, שמור על בריאותם עם עזרתו של DSI ViruSeal!
יתרונות:
- מבטיח איטום מאובטח של פערים וחללים בשתלים.
- מונע את הסיכון לזיהומים.
- ללא אנטיביוטיקה.
- פורמולה דוחת חיידקים.
- מושלם לשחזורים הכוללים עבודה עם ברגים.
- אריזה סטרילית.
- הגנה מלאה על השתל.